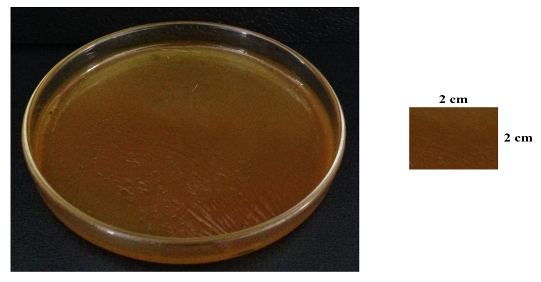

Faculty of Pharmacy and Sino-Thai Traditional Medicine Research Center (Cooperation between Rangsit University, Harbin Institute of Technology, and Heilongjiang University of Chinese Medicine), Rangsit University, Pathum Thani 12000, Thailand.
Email: jirapornchai.s@rsu.ac.th
Received: 28 May 2014 Revised and Accepted: 09 Jul 2014
ABSTRACT
Objective: This work aimed to study of surface morphology of the Plai patch, incorporating the crude Plai oil in polymer blends comprised of chitosan and polyvinyl alcohol using glycerine as plasticizer by SEM method.
Methods: We prepared the patch from polymer blends comprised of chitosan, polyvinyl alcohol, and glycerine by adding the crude Plai oil into this polymer blends solution, and then transferred to dry into hot air oven to produce dark yellow patch which called Plai patch. Then, this Plai patch was studied the in vitro release using Franz cell diffusion apparatus for 24 hours. The Plai patch was removed from equipment and photographed by scanning electron microscope (SEM) to study the morphology of this patch after compound D release from patch.
Results: After the release of compound D, the morphology of the Plai patch was visualized by SEM. The morphology of Plai patch made from polymer blends between chitosan, polyvinyl alcohol, and glycerine had various numbers of pores, suggesting that the compound D release occur mainly this patch surfaces and its might diffused through the matrix pores due to the active compound solubilization in the receptor medium, isotonic phosphate buffer pH 7.4: ethanol = 8:2.
Conclusion: The Plai patch might swell and release the compound D, main active compound in Plai from this patch when the Plai patch absorbed the moisture and fluid from receptor medium. This might contributed the pore in surface of Plai patch.
Keyword: Morphology study, Plai, Patch, PVA.
INTRODUCTION
Zingiber cassumunar Roxb., commonly name in Thai known as plai (Figure 1), is widely used in folklore remedies as a single plant or as component of herbal recipes in Thailand. It can use for treatments of inflammation, sprains and strains, rheumatism, muscular pain, wounds, and asthma, cough and respiratory problems, and as a mosquito repellant, a carminative, a mild laxative and an antidysenteric agent [1]. The essential oil exhibited a topical anti-inflammatory effect when tested using various experimental models [2-5]. Individual assessment of the topical anti-inflammatory activity of the major components of the oil demonstrated that (E)-4-(3,4-dimethoxy phenyl)but-3-en-l-ol (compound D), (E)-1-(3,4-dimethoxy phenyl)butadiene (DMPBD), (E)-4-(3, 4-dimethoxy phenyl)but-3-en-l-yl acetate, (E)-4-(3,4-dimethoxyphenyl) but-3-en-1-O-β-D-glucopyranoside, (E)-4-(2,4,5-trimethoxyphenyl)-but-1,3-diene, (E)-trans-3-(3,4-dimethoxy phenyl)-4-[(E)-3,4-dimethoxy styryl] cyclohex-1-ene, and (E)-trans-3-(4-hydroxy-3- methoxyphenyl)-4-[(E)-3,4-dimethoxystyryl]cyclohex-1-ene significantly inhibited oedema formation [6-8], whereas sabinene and terpinen-4-ol were inactive, but they were reported as antimicrobial activities in comparison with commercial terpinen-4-ol [1, 9, 10].

Fig. 1: Fresh Zingiber cassumunar Roxb. (Plai, left) and Zingiber cassumunar Roxb. Powder (Plai powder, right)
Scanning electron microscope (SEM) is a type of electron microscope that uses a focused beam of high-energy electrons to produce images of a sample by variety of signals. The electrons interact with atoms in the sample, producing various signals that can be detected and that contain information about the external morphology or texture, chemical composition, and crystalline structure and orientation of materials making up the sample [11]. In application, the image are collected over a selected area of the surface’s sample, thus many publication uses this technique to study the morphology and topology of sample [12-15].
This work mainly studied the morphology of Plai patch which incorporated the crude Plai oil into polymer blends solution between chitosan, polyvinyl alcohol, and glycerine. This Plai patch was studied the in vitro release of compound D for 24 hours by Franz cell diffusion apparatus having the isotonic phosphate buffer pH 7.4: ethanol = 8:2 as receptor medium. The Plai patch was photographed by SEM technique.
MATERIALS AND METHODS
Materials
Plai powder was purchased from Charoensuk Osod, Thailand. Chitosan powder was purchased from Seafresh Industry Public Co., Ltd, Thailand. Polyvinyl alcohol and glycerine were purchased from Sigma-Aldrich, USA. Ethanol was of analytical grade obtained from Merck KGaA (Germany). The ultrapure water was produced by Puris, Expe-UP water system (model: Expe-UP series, Korea) that had been purified to stringent specifications with 18.2 MΩ∙cm at 25ºC of resistivity, 5 – 10 ppb of total organic carbon (TOC), <0.05 ppb of inorganics, and <1 cfu/mL of bacteria.
Plai patch preparation
The Plai patch was made from crude Plai oil mixed into polymer blends solution between of chitosan, polyvinyl alcohol, and glycerine. The crude Plai oil was mixed together into polymer blends solution that comprised of 2 g of 3.5%w/v chitosan in distilled water comprised of 1% acetic acid, 5 g of 20%w/v polyvinyl alcohol in distilled water, and glycerine was used as plasticizer. The Plai patch could produce by transfers the crude Plai oil-mixed polymer blends solution into Petri-dish and dry in hot air oven at 70±2ºC for 5 hours.
The in vitro release studies
The Plai patch was studied the in vitro release behavior of compound D using a modified Franz-type diffusion cell having isotonic phosphate buffer pH 7.4: ethanol = 8:2 as receptor medium, controlled with a water jacket at 37±0.5ºC, and constantly stirred at 600 rpm with a magnetic stirrer for 24 hours. However, this work reported only the surface morphology of Plai patch after compound D release from Plai patch. Thus, the in vitro release profile of compound D might be reported in future publication.
SEM photography
The Plai patch from in vitro study for 24 hours was placed onto copper stub and then was coated with gold in a sputter coater. It was photographed surface of Plai patch under SEM (model: Quanta 400, FEI, Czech Republic) with high vacuum and high voltage of 20 kV condition, and using everhart thornley detector (ETD).
RESULTS AND DISCUSSION
The appearances of Plai patches made from polymer blends consisted of chitosan and polyvinyl alcohol using glycerine as plasticizer was photographed by digital camera (Figure 2).
Fig. 2: The appearances of Plai patch made from polymer blends between chitosan and polyvinyl alcohol using glycerine as plasticizer photographed by digital camera, this picture was modified from previous publication [16].
Before in vitro release of compound D, the surface of Plai patch made from polymer blends consisted of chitosan and polyvinyl alcohol using glycerine as plasticizer that photographed by SEM technique was represented in previous publication [16]. This picture can confirmed the crude Plai oil, mainly compound in Plai entrapment in Plai patch was made from chitosan and polyvinyl alcohol using glycerine as plasticizer. After in vitro release of compound D, 24 hours, this work, many pores were found in surface morphology of Plai patch under SEM photography (Figure 3).

Fig. 3: The surface appearances of Plai patch made from polymer blends between chitosan and polyvinyl alcohol using glycerine as plasticizer at ×500 (left) and ×1,500 (right) under SEM study
This is due to the compound D release from Plai patch. When the Plai patch absorbed the receptor medium (isotonic phosphate buffer pH 7.4: ethanol = 8:2) in patch, the Plai patch might swell and release the compound D from patch. Thus, we could found many pores in patch which are shown in Figure 3. However, the release behavior of compound D from this Plai patch might be reported in future publication.
CONCLUSION
We successfully prepared the Plai patch made from polymer blends consisted of chitosan and polyvinyl alcohol using glycerine as plasticizer. It had dark yellow Plai patch under digital camera. When the compound D, mainly compound in Plai released from patch, this Plai patch had a great number of pores that photographed by SEM method. Moreover, the in vitro release study for this Plai patch might be reported in further study.
CONFLICT OF INTERESTS
Declared None
ACKNOWLEDGEMENTS
The authors would like to acknowledge the Faculty of Pharmacy and the Research Institute of Rangsit University for financial supports (grant no. 74/2555).
NOTE
This report was related with another publication by our group research in entitle of “MORPHOLOGY STUDY OF PLAI PATCH BY THE SCANNING ELECTRON MICROSCOPE. PART I: CHITOSAN AND HYDROXYPROPYLMETHYLCELLULOSE BLENDS”.
REFERENCES